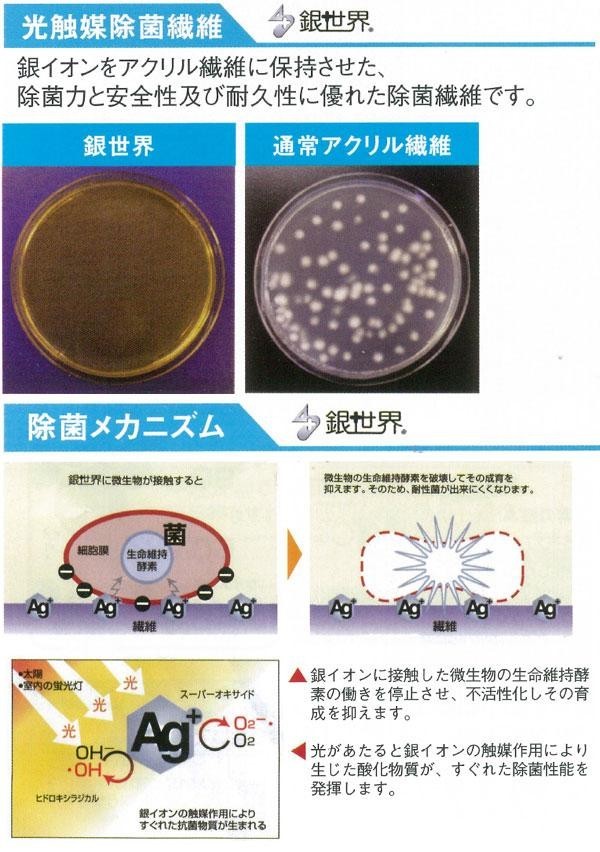

|
| 【取扱い時の注意】 ・脱水機による脱水は可能ですが、乾燥機のご使用はお控えください。 ・漂白剤やベンジン等、薬品の使用は変質の恐れがありますので、ご使用にならないでください。 ・裏面は水漏れを防ぐ特殊加工をしていますが、オシッコをマットの端にすると溢れ出て裏面に廻り、床が濡れることがありますので注意をしてください。 ・裏地の特殊加工で滑りにくくなっていますが、床面の状態により一定ではありません。万一の場合を考えて、市販の滑り止めテープを使用することはお勧めします。 ・毛が絡み付いた場合、掃除機などで吸い取ってください。取れにくい場合はラバー製の抜け毛取りや粘着テープ・粘着性の掃除具をご使用ください。 ・繊維アレルギー等をお持ちの場合はご使用時に注意をしてください。 ・しばらくの間、毛玉が出ることがあります。その場合は掃除機で吸い取ってください。品質上の欠陥ではありません。 ・長期の使用にあたって、防水生地に傷や穴が開くと防水機能が失われる場合がありますのでご注意ください。 |
|
 |
 |
 |
 |